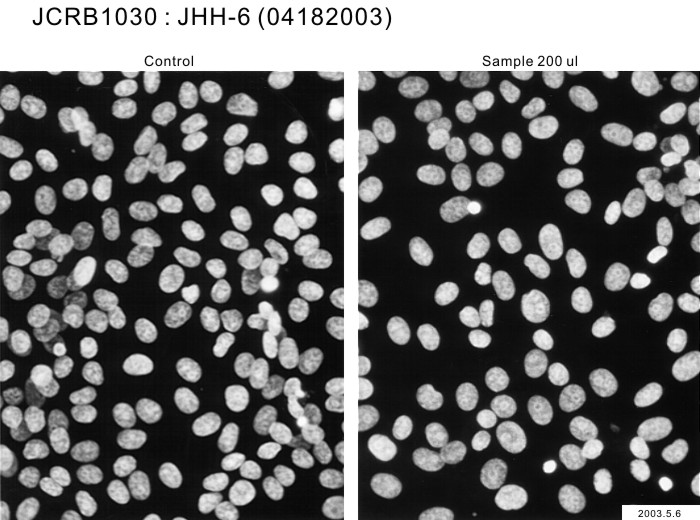

JCRB1030 JHH-6
細胞情報
Important Notice(s)On the agreement for distribution of JHH series cell lines, NOZ and OZ
細胞種類:一般細胞 (細胞分譲手数料はこちら)
| 細胞番号(JCRB) | JCRB1030 | 細胞名 | JHH-6 |
|---|---|---|---|
| 生物種(日本語) | ヒト | 組織名(日本語) | 肝臓, 胆嚢 |
| コメント(日本語) | 肝細胞がん | プロフィール | Human hepatocellular carcinoma cell line. |
| 別名 | 動物名 | human | |
| 系統名 | 学名・属名 | Homo | |
| 学名・種小名 | sapiens | 性別 | F |
| 年齢・月齢 | 57 | 細胞識別情報 | available |
| (癌)原発組織名 | liver, gallbladder | 病歴情報 | anhepatic liver carcinoma, hetocellular carcinoma (Ed.II). HBs-Ag(-), HBs-Ab(-), HBe-Ag(-), HBc-Ab(-), AFP(ND), CEA 4.6ng/ml. |
| 転移の有無(Y/N) | (癌)転移組織名 | ||
| 遺伝的性質 | HBV-DNA was not integrated | 細胞寿命 | infinite |
| クライシスPDL | 形態 | ephitherial-like structure | |
| 一般性状 | Undifferentiated morphology observed. Albumin, AFP and CEA were not observed in the supernatant of the cell culture but ferritin was observed (6.7 ng/ml). HBs-Ag(-), HBs-Ag(-). | 細胞分類 | tumor |
| 細胞樹立者名 | Matsuura,T. & Nagamori,S. | 細胞寄託者 | Nagamori,S. |
| 分譲時制限 | Require negotiation and agreement from Dr.Nagamori before shipping. | コメント | Cell Bank will handle to get the approval but the depositor may contact to the requested person directly. |
| 入手年 | 2001 | 培養培地 | Williams'E medium with 10% fetal calf serum. |
| 継代方法 | Cells are harvested after treatment with 0.25% trypsin and 0.02% EDTA. | 継代時細胞数 | not defined |
| 人種 | Japanese | 炭酸ガス濃度 | 5 % |
| 採取組織名 | 組織型 | undifferentiated hepato cellular carcinoma |
| ウイルスDNA・RNA検出検査 (Detection of virus genome fragment by Real-time PCR) | |||||||||
|---|---|---|---|---|---|---|---|---|---|
| ウイルスDNA 検出検査 |
tested | ウイルスRNA 検出検査 |
tested | ||||||
| CMV | - | parvoB19 | - | HCV | - | HTLV-1 | - | ||
| EBV | - | HBV | - | HIV-1 | - | HTLV-2 | - | ||
| HHV6 | - | HTLV-1 | - | HIV-2 | - | HAV | - | ||
| HHV7 | - | HTLV-2 | - |
-/negative. +/positive. nt/not tested. (positive (+) does not immediately mean the production of infectious viral particles.) |
|||||
| BKV | - | HIV-1 | - | ||||||
| JCV | - | HIV-2 | - | ||||||
| ADV | - | HPV18 | - | ||||||
| Notes | |||||||||
| Reference | |
|---|---|
| Pubmed id:1701409 | Integration of hepatitis B virus DNA into cells of six established human hepatocellular carcinoma cell lines. Fujise K,Nagamori S,Hasumura S,Homma S,Sujino H,Matsuura T,Shimizu K,Niiya M,Kameda H,Fujita K Hepatogastroenterology. 1990 Oct;37(5):457-60 |
| Pubmed id:2484807 | [Protein secretion of human cultured liver cells]. Nagamori S,Fujise K,Hasumura S,Homma S,Sujino H,Matsuura T,Shimizu K,Niiya M,Kameda H Hum Cell. 1988 Dec;1(4):382-90 |
| Research results by users. Click! | |
|---|---|
| Pubmed id:40313132 |
Cancer-Type-Specific DNA Methylation Is a Source of Vulnerability in Liver Cancer Cells. Minowa K,Seki M,Nagai Y,Yamashita S Cancer Sci. 2025 May 2;(): |
| Pubmed id:24574752 |
Bortezomib effect on E2F and cyclin family members in human hepatocellular carcinoma cell lines. Baiz D,Dapas B,Farra R,Scaggiante B,Pozzato G,Zanconati F,Fiotti N,Consoloni L,Chiaretti S,Grassi G World J Gastroenterol. 2014 Jan 21;20(3):795-803 |
| Pubmed id:23967134 |
Specific inhibition of the redox activity of ape1/ref-1 by e3330 blocks tnf-α-induced activation of IL-8 production in liver cancer cell lines. Cesaratto L,Codarin E,Vascotto C,Leonardi A,Kelley MR,Tiribelli C,Tell G PLoS One. 2013;8(8):e70909 |
| Pubmed id:24116172 |
The expression of CD90/Thy-1 in hepatocellular carcinoma: an in vivo and in vitro study. Sukowati CH,Anfuso B,Torre G,Francalanci P,Crocè LS,Tiribelli C PLoS One. 2013;8(10):e76830 |
| Pubmed id:22309595 |
Fibroblast growth factor 19 expression correlates with tumor progression and poorer prognosis of hepatocellular carcinoma. Miura S,Mitsuhashi N,Shimizu H,Kimura F,Yoshidome H,Otsuka M,Kato A,Shida T,Okamura D,Miyazaki M BMC Cancer. 2012 Feb 6;12():56 |
| Pubmed id:21831731 |
Effects of E2F1-cyclin E1-E2 circuit down regulation in hepatocellular carcinoma cells. Farra R,Dapas B,Pozzato G,Scaggiante B,Agostini F,Zennaro C,Grassi M,Rosso N,Giansante C,Fiotti N,Grassi G Dig Liver Dis. 2011 Dec;43(12):1006-14 |
| Pubmed id:21882038 |
Mitochondrial bioenergetic profile and responses to metabolic inhibition in human hepatocarcinoma cell lines with distinct differentiation characteristics. Domenis R,Comelli M,Bisetto E,Mavelli I J Bioenerg Biomembr. 2011 Oct;43(5):493-505 |
| Pubmed id:20144681 |
Serum response factor depletion affects the proliferation of the hepatocellular carcinoma cells HepG2 and JHH6. Farra R,Dapas B,Pozzato G,Giansante C,Heidenreich O,Uxa L,Zennaro C,Guarnieri G,Grassi G Biochimie. 2010 May;92(5):455-63 |
| Pubmed id:20200618 |
Galectin-1 and its involvement in hepatocellular carcinoma aggressiveness. Spano D,Russo R,Di Maso V,Rosso N,Terracciano LM,Roncalli M,Tornillo L,Capasso M,Tiribelli C,Iolascon A Mol Med. 2010 Mar;16(3-4):102-15 |
| Pubmed id:20044606 |
Infrequent amplification of JUN in hepatocellular carcinoma. Endo M,Yasui K,Nakajima T,Gen Y,Tsuji K,Dohi O,Zen K,Mitsuyoshi H,Minami M,Itoh Y,Taniwaki M,Tanaka S,Arii S,Okanoue T,Yoshikawa T Anticancer Res. 2009 Dec;29(12):4989-94 |
| Pubmed id:19041685 |
Bortezomib arrests the proliferation of hepatocellular carcinoma cells HepG2 and JHH6 by differentially affecting E2F1, p21 and p27 levels. Baiz D,Pozzato G,Dapas B,Farra R,Scaggiante B,Grassi M,Uxa L,Giansante C,Zennaro C,Guarnieri G,Grassi G Biochimie. 2009 Mar;91(3):373-82 |
| Pubmed id:19142034 |
Contribution of AP-1 interference induced by TAC-101 to tumor growth suppression in a hepatocellular carcinoma model. Eshima K,Fukaya S,Sugimoto A,Mori T,Yokoi H,Yamamoto Y,Sugiura S,Honda S,Masuko N,Murakami K,Yamasaki Y,Kagechika H Tumour Biol. 2009;30(1):1-7 |
| Pubmed id:17825975 |
The expression levels of the translational factors eEF1A 1/2 correlate with cell growth but not apoptosis in hepatocellular carcinoma cell lines with different differentiation grade. Grassi G,Scaggiante B,Farra R,Dapas B,Agostini F,Baiz D,Rosso N,Tiribelli C Biochimie. 2007 Dec;89(12):1544-52 |
| Pubmed id:15349899 |
Proteomic signature corresponding to alpha fetoprotein expression in liver cancer cells. Yokoo H,Kondo T,Fujii K,Yamada T,Todo S,Hirohashi S Hepatology. 2004 Sep;40(3):609-17 |
| Pubmed id:10766424 |
Involvement of insulin-like growth factor binding protein-3 in the retinoic acid receptor-alpha-mediated inhibition of hepatocellular carcinoma cell proliferation. Murakami K,Matsuura T,Hasumura S,Nagamori S,Yamada Y,Saiki I Cancer Lett. 2000 Apr 3;151(1):63-70 |
| Pubmed id:10933057 |
Invasiveness of hepatocellular carcinoma cell lines: contribution of membrane-type 1 matrix metalloproteinase. Murakami K,Sakukawa R,Ikeda T,Matsuura T,Hasumura S,Nagamori S,Yamada Y,Saiki I Neoplasia. 1999 Nov;1(5):424-30 |
| Pubmed id:9446792 |
Cyclin E overexpression responsible for growth of human hepatic tumors with p21WAF1/CIP1/SDI1. Tsuji T,Miyazaki M,Fushimi K,Mihara K,Inoue Y,Ohashi R,Ohtsubo M,Hamazaki K,Furusako S,Namba M Biochem Biophys Res Commun. 1998 Jan 14;242(2):317-21 |
| Pubmed id:8835345 |
Persistence of hepatitis C virus RNA in established human hepatocellular carcinoma cell lines. Tsuboi S,Nagamori S,Miyazaki M,Mihara K,Fukaya K,Teruya K,Kosaka T,Tsuji T,Namba M J Med Virol. 1996 Feb;48(2):133-40 |
| Pubmed id:1701409 |
Integration of hepatitis B virus DNA into cells of six established human hepatocellular carcinoma cell lines. Fujise K,Nagamori S,Hasumura S,Homma S,Sujino H,Matsuura T,Shimizu K,Niiya M,Kameda H,Fujita K Hepatogastroenterology. 1990 Oct;37(5):457-60 |
| Pubmed id:none |
樹立ヒト肝癌株細胞中のB型肝炎ウイルスゲノム 藤瀬 清隆, 藤多 和信, 永森 静志, 蓮村 哲, 本間 定, 筋野 甫, 松浦 知和, 清水 恵一郎, 新谷 稔, 大野 典也, 亀田 治男 肝臓 29(5), 697-698 (1988) |
| Pubmed id:none |
株化肝細胞癌の遺伝子発現 Gene expression in human hepatocellular carcinoma cell lines 村上 孝司 山田 雄次 済木 育夫 松浦 知和 蓮村 哲 永森 静志 組織培養研究 18(3), 221-228 (1999) |
| Images |
|---|
![]() ![]() ![]() ![]() ![]() ![]() ![]() ![]() ![]() ![]() ![]() ![]() ![]() ![]() ![]() ![]() ![]() ![]() ![]() ![]() |
| Movies |
|---|
|
|
LOT Information
生細胞率、増殖速度、細胞濃度はバンクでのロット作製時の実測値として記していますが、保証値ではございません。また、倍加時間は継代間で計測したラフな値です。Viability/Growth rate/Cell number are represented as actual values measured at lot presentation in JCRB, but are not guaranteed values. Additionally, the doubling time is a rough value measured during passages.
| 細胞番号 | JCRB1030 | 細胞名 | JHH-6 |
|---|---|---|---|
| 培養ロット番号 | 09082009 | 培養種別 | distribution |
| 培地 | Williamms' E medium with 10% fetal bovine serum (Intergen RB52305). | 培養温度 | 37 C |
| 継代時細胞数(濃度) | 1.6x10^4 cells/sq.cm | 継代方法 | Cells were harvested after treatment with 0.25%(GIBCO) trypsin and 0.02% EDTA. |
| 増殖速度 | NT | 凍結時生細胞濃度 | 2.0x10^6 |
| 凍結時生細胞率 | 98.8 | 使用抗生物質 | NT |
| 継代数 | p9* | PDL数(プライマリ) | NT |
| マイコプラズマ検出 | - | 細菌汚染検出 | - |
| 真菌汚染検出 | - | アイソザイム検査・動物名 | NT |
| 染色体モード | NT | 染色体情報 | NT |
| 表面抗原 | NT | DNA Profile (STR) | D5S818:10,11 D13S317:11,12,13 D7S820:11 D16S539:10 VWA:14,18 TH01:7,9 AM:X TPOX:8,9 CSF1PO:10,12 |
| 接着性 | Yes | 導入外部遺伝子 | NT |
| 凍結培地 | Cell Banker BLC-1(Nihon Zenyaku Industries) | 炭酸ガス濃度 | 5 % |
| 解凍後生細胞率 | 追加情報 |
| Images |
|---|
![]() ![]() |
| 細胞番号 | JCRB1030 | 細胞名 | JHH-6 |
|---|---|---|---|
| 培養ロット番号 | 04182003 | 培養種別 | distribution |
| 培地 | William's E medium with 10% fetal calf serum (Intergen RB52305). | 培養温度 | 37 C |
| 継代時細胞数(濃度) | 1.0 x 10^4 cells/sq.cm. | 継代方法 | Cells harvested after treatment with 0.2% trypsin. Medium change twice a week. Subculture every 4-5 days. |
| 増殖速度 | NT | 凍結時生細胞濃度 | 1.1 x 10^6 |
| 凍結時生細胞率 | 98.3 | 使用抗生物質 | free |
| 継代数 | P8* | PDL数(プライマリ) | NT |
| マイコプラズマ検出 | - | 細菌汚染検出 | - |
| 真菌汚染検出 | - | アイソザイム検査・動物名 | G6PD(type B), NP, LDH examined. Human not HeLa. |
| 染色体モード | NT | 染色体情報 | NT |
| 表面抗原 | NT | DNA Profile (STR) | |
| 接着性 | Yes | 導入外部遺伝子 | NT |
| 凍結培地 | culture medium containing 5% DMSO. | 炭酸ガス濃度 | 5 % |
| 解凍後生細胞率 | 追加情報 |
| Images |
|---|
![]() ![]() ![]() ![]() ![]() ![]() ![]() |
| 細胞番号 | JCRB1030 | 細胞名 | |
|---|---|---|---|
| 培養ロット番号 | 03282003 | 培養種別 | distribution |
| 培地 | William's E medium with 10% fetal bovine serum (FBS lot; BioWhittaker 0S069F) | 培養温度 | 37 C |
| 継代時細胞数(濃度) | 2-3 x 10^4 cells/ml | 継代方法 | 0.25% trypsin and 0.02% EDAT |
| 増殖速度 | D.T. = ca. 30 hrs | 凍結時生細胞濃度 | 9.6 x 10^5 |
| 凍結時生細胞率 | 86.4 | 使用抗生物質 | free |
| 継代数 | Unknown (9 at bank) | PDL数(プライマリ) | |
| マイコプラズマ検出 | - | 細菌汚染検出 | - |
| 真菌汚染検出 | - | アイソザイム検査・動物名 | Confirmed as human by NP, G6PD (type B), LD. |
| 染色体モード | 染色体情報 | ||
| 表面抗原 | DNA Profile (STR) | ||
| 接着性 | Yes | 導入外部遺伝子 | |
| 凍結培地 | 10% DMSO, 20% FCS-culture | 炭酸ガス濃度 | 5% |
| 解凍後生細胞率 | 追加情報 |
| 細胞番号 | JCRB1030 | 細胞名 | JHH-6 |
|---|---|---|---|
| 培養ロット番号 | 05182017 | 培養種別 | distribution |
| 培地 | Williams'E medium with 10% fetal bovine serum (FBS; Sigma Cat. # 172012) | 培養温度 | 37 C |
| 継代時細胞数(濃度) | 1.2.6 - 9.3 x 10^4 cells/ml | 継代方法 | Cells were harvested after treatment with 0.25% trypsin and 0.02% EDTA. |
| 増殖速度 | approx. 21 hrs. | 凍結時生細胞濃度 | 1.9 x 10^6 |
| 凍結時生細胞率 | 95.9 | 使用抗生物質 | free |
| 継代数 | Unknown (9 at bank) | PDL数(プライマリ) | |
| マイコプラズマ検出 | - | 細菌汚染検出 | - |
| 真菌汚染検出 | - | アイソザイム検査・動物名 | |
| 染色体モード | 染色体情報 | ||
| 表面抗原 | DNA Profile (STR) | ||
| 接着性 | Yes | 導入外部遺伝子 | |
| 凍結培地 | 10% DMSO, 20% FBS - Williams'E medium | 炭酸ガス濃度 | 5% |
| 解凍後生細胞率 | 95.9 | 追加情報 |
| 細胞番号 | JCRB1030 | 細胞名 | JHH-6 |
|---|---|---|---|
| 培養ロット番号 | 06212018 | 培養種別 | distribution |
| 培地 | Williams'E medium with 10% fetal bovine serum (FBS; Sigma Cat. # 172012) | 培養温度 | 37 C |
| 継代時細胞数(濃度) | 2.0 - 3.4 x 10^4 cells/mL | 継代方法 | Cells were harvested after treatment with 0.25% trypsin and 0.02% EDTA. |
| 増殖速度 | approx. 29 hrs. | 凍結時生細胞濃度 | 8.7 x 10^5 |
| 凍結時生細胞率 | 使用抗生物質 | free | |
| 継代数 | Unknown (9 at bank) | PDL数(プライマリ) | |
| マイコプラズマ検出 | - | 細菌汚染検出 | - |
| 真菌汚染検出 | - | アイソザイム検査・動物名 | |
| 染色体モード | 染色体情報 | ||
| 表面抗原 | DNA Profile (STR) | ||
| 接着性 | Yes | 導入外部遺伝子 | |
| 凍結培地 | 10% DMSO, 20% FBS - Williams'E medium | 炭酸ガス濃度 | 5% |
| 解凍後生細胞率 | 95.5 | 追加情報 |